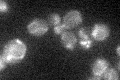
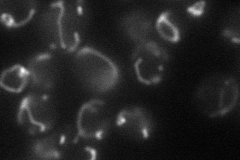

View description
Mitochondrial integral inner membrane protein required for membrane insertion of C-terminus of Cox2p; interacts genetically and physically with Mss2p and Pnt1p; similar to S. cerevisiae Oxa1, N. crassa Oxa2p, and E. coli YidC
Localization:
Intensity:
Fold change:
Significance:
-
C’ GFP library in SD
mitochondria18.84 -
N' NOP1pr-GFP in SD
mitochondria48.3862 -
N' TEF2pr-mCherry in SD

missing0 -
N' NATIVEpr-GFP in SD

missing0 -
N' TEF2pr-VC and Cyto-VN in SD

#N/A0 -
C’ GFP library in SD+DTT

mitochondria19.661.04No -
C’ GFP library in SD+H2O2

mitochondria18.240.96No -
C’ GFP library in Starvation Media

mitochondria19.961.05No -
C’ GFP library on the background of Pup2-DaMP

mitochondria -
C’ GFP library on the background of CCT mutant

mitochondria16.53050.87714No
